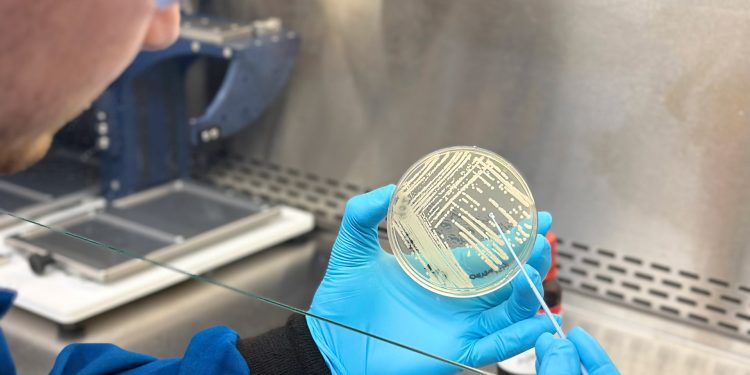

Kinvard Bio co-founder Ben Tresco inspects a colony of drug-resistant bacteria.
Health
Harvard startup creating a new class of antibiotics
Compounds show promise against drug-resistant infections, diseases
When penicillin, the first antibiotic approved for widespread use, became available in the 1940s, The New York Times reported it as “the most powerful germ killer ever discovered.” In 1945, many of the scientists involved in developing it were awarded a Nobel Prize for its significant impact on medicine. Humans had entered the antibiotic age, in which they could survive any number of infections and illnesses that had once been fatal.
But today, the picture has become much more complicated.
Antibiotics work by binding to or harming different parts of a germ’s structure. Penicillin, for example, binds to a part of the bacterial cell wall and degrades it. But germs are smart, and over time they can develop resistance mechanisms — like changing the target of an antibiotic so it can no longer bind properly or pumping the antibiotic out of the germ’s cell walls. These resistance mechanisms get passed on to other germs, meaning antibiotics once effective against an infection may not be any longer.
That has created one of the most serious health crises of our time. Antibiotic resistance, according to the World Health Organization, was responsible for more than a million deaths worldwide in 2019 and contributed to nearly 5 million deaths. Meanwhile, new classes of antibiotics are being approved at very low rates. Between 2017 and 2022, just a dozen antibiotics were approved worldwide and only two of those were from new classes that work in a different way than existing medicines.
Enter Kinvard Bio, a biotechnology company that on Monday announced its launch out of the Myers Lab in the Department of Chemistry and Chemical Biology at Harvard University. The startup is creating a new class of antibiotics in the hopes of treating drug-resistant infections and diseases.
Andrew Myers, the Amory Houghton Professor of Chemistry and Chemical Biology at Harvard, had already established himself as one of the world’s pre-eminent synthetic chemists when he decided to focus much of his lab’s efforts on addressing the global health crisis caused by antimicrobial resistance. Chemists have long come to Harvard to learn from Myers. And for over a decade, those scientists have contributed to innovations that can impact this significant unmet health need.
The lab’s research is not only creating new compounds that could alleviate an intractable problem but also cultivating the next generation of scientists who can continue confronting the challenge. Kelvin Wu, a Kinvard Bio co-founder who co-led the research team as a graduate student in the Myers Lab, hopes the company’s platform will help solve the “resistance crisis,” he says. “Antibiotic discovery is a global problem that I personally am very worried about.”
Kinvard Bio CEO Lloyd Payne echoed Wu’s concerns about treatment options becoming more limited. “There is a critical need for continued innovation to deliver new antibacterials into the pipeline to ensure that we are able to successfully treat challenging drug-resistant infections for generations to come.”
The new medicines that Kinvard Bio are developing focus on the bacterial ribosome, an antibiotic target that is highly clinically validated, according to Payne. Though there are already a number of antibiotics that target the ribosome, Kinvard Bio’s antibiotics — called the oxepanoprolinamides — are structurally preorganized for highly effective binding to the target.
“The bacterial ribosome is an incredibly important target as it is clinically validated and essential across a broad range of clinically relevant pathogens, but the important thing — and this really is key — is the fact that the oxepanoprolinamides bind to the ribosome in a highly differentiated way,” Payne said. “There is further work to do to progress the program into human clinical trials, but this binding mode affords promising potential for the avoidance of pre-existing resistance to currently used antibiotics.”
The Myers Lab has been working on developing this class of compounds for more than a decade. But they have even deeper roots — dating back to the 1960s, not too long after penicillin ushered the world into the antibiotic age. In 1964, the Federal Drug Administration approved lincomycin — an antibiotic isolated from a soil microbe — a significant breakthrough, says Payne, because, at that time, it was an alternative for people allergic to penicillin.
“This was an underexploited class of antibiotics that was ripe for revitalization,” said Wu.
Myers’ team received funding and other support from Harvard’s Blavatnik Biomedical Accelerator to help further their work, including the synthesis and testing of new compounds, leading to a 2021 paper in Nature.
For some elements of the design, the team had to invent entirely new chemistry. “One of the reasons that this program has been successful is our ability to put the molecules together very efficiently. Using chemical synthesis, we can start with simple building blocks and then stitch them together into a really complex molecule,” said Ben Tresco, Kinvard Bio co-founder, who led the research team along with Wu as a graduate student in the Myers Lab. “The reason these molecules are so different from their predecessors — the other molecules that bind in this site — is that they are so well optimized for binding to the bacterial ribosome.”
In 2024, the team received a $1.2 million grant from the Combating Antibiotic-Resistant Bacteria Biopharmaceutical Accelerator (CARB-X) and additional support from the Blavatnik Biomedical Accelerator to further develop the antibiotics. Kineticos Life Sciences, an investment firm focused on companies in oncology, rare diseases, and antimicrobial resistance, through its relationship with CARB-X, was introduced to the technology via Harvard’s Office of Technology Development (OTD). Kineticos incubated and funded the company through the Kineticos AMR Accelerator Fund I.
“OTD was instrumental in making sure that investors were aware of what the research team was working on and that there was great potential for a new company to be formed,” said Curtis Keith, the chief scientific officer at the Blavatnik Biomedical Accelerator.
Early preclinical studies have shown the antibiotics are active against a broad range of pathogens implicated in a range of infections, including those resistant to other antibiotics.
The startup is initially building a pipeline focused on acute and chronic infections associated with high unmet patient need, such as bacterial pneumonia, complicated urinary tract infections, and chronic respiratory infections, with the aim of developing both intravenous and oral formulations. Both routes of drug delivery are important because oral antibiotics can be effective in reducing hospital admissions and lengths of hospitalization. Spending more time in a hospital increases the risk of acquiring new infections. Eventually, applications could expand to include notoriously challenging chronic infections such as nontuberculous mycobacteria lung disease.
According to Keith, the science is in line with what the Myers Lab is all about — applying synthetic chemistry to tackle some of the world’s most pressing challenges. “They’re not just conducting chemistry that will remain in the lab; the research team is focused on developing practical solutions that could lead to effective and accessible antibiotics.”
Research reported in this article is funded by the National Institutes of Health and by CARB-X, whose funding for this project is provided in part with federal funds from the U.S. Department of Health and Human Services; Administration for Strategic Preparedness and Response; Biomedical Advanced Research and Development Authority; Wellcome; Germany’s Federal Ministry of Education and Research; and the UK Department of Health and Social Care as part of the Global Antimicrobial Resistance Innovation Fund.